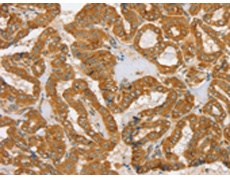
一抗

中文名稱: 兔抗PDP1多克隆抗體
英文名稱: Anti-PDP1 rabbit polyclonal antibody
別 名: PDH; PDP; PDPC; PPM2C
相關(guān)類別: 一抗
儲 存: 冷凍(-20℃)
宿 主: Rabbit
抗 原: PDP1
反應(yīng)種屬: Human, Mouse, Rat
標 記 物: Unconjugate
克隆類型: rabbit polyclonal
技術(shù)規(guī)格
|
Background: |
Pyruvate dehydrogenase (E1) is one of the three components (E1, E2, and E3) of the large pyruvate dehydrogenase complex. Pyruvate dehydrogenase kinases catalyze phosphorylation of serine residues of E1 to inactivate the E1 component and inhibit the complex. Pyruvate dehydrogenase phosphatases catalyze the dephosphorylation and activation of the E1 component to reverse the effects of pyruvate dehydrogenase kinases. |
|
Applications: |
ELISA, IHC |
|
Name of antibody: |
PDP1 |
|
Immunogen: |
Fusion protein of human PDP1 |
|
Full name: |
pyruvate dehyrogenase phosphatase catalytic subunit 1 |
|
Synonyms: |
PDH; PDP; PDPC; PPM2C |
|
SwissProt: |
Q9P0J1 |
|
ELISA Recommended dilution: |
2000-5000 |
|
IHC positive control: |
Human thyroid cancer and human cervical cancer |
|
IHC Recommend dilution: |
30-150 |

 購物車
購物車 幫助
幫助
 021-54845833/15800441009
021-54845833/15800441009